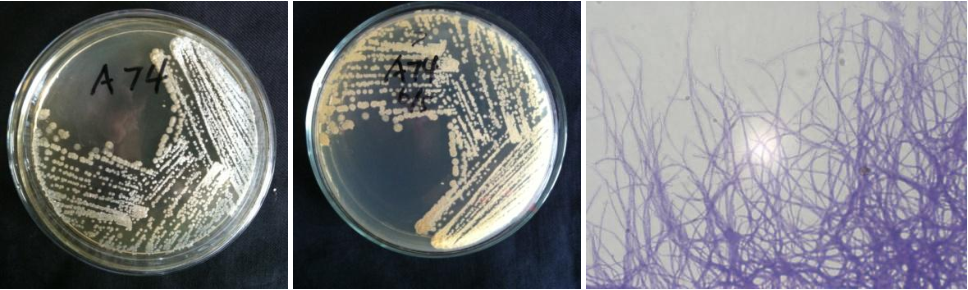

Loading...
| StrainNO | A74 |
| Classification | Streptacidiphilus |
| 16s rDNA sequence | CGAACGCTGGCGGCGTGCTTAACACATGCAAGTCGAACGGTGAAGCCCTTCGGGGTGGATCAGTGGCGAACGGGTGAGTAACACG TGGGTAATCTGCCCTGCATTCTGGGACAAGCCTTGGAAACGAGGTCTAATACCGGATACGACGCATCTCCGCATGGGGTGTGCGT GGAAAGCTCCGGCGATGCAGGATGAACCCGCGGCCTATCAGCTTGTTGGTGGGGTGATGGCCTACCAAGGCGACGACGGGTAGCC GGCCTGAGAGGGCGACCGGCCACACTGGGACTGAGACACGGCCCAGACTCCTACGGGAGGCAGCAGTGGGGAATATTGCACAATG GGCGAAAGCCTGATGCAGCGACGCCGCGTGAGGGATGACGGCCTTCGGGTTGTAAACCTCTTTCAGCAGGGAAGAAGCGCAAGTG ACGGTACCTGCAGAAGAAGCACCGGCTAACTACGTGCCAGCAGCCGCGGTAATACGTAGGGTGCGAGCGTTGTCCGGAATTATTG GGCGTAAAGAGCTCGTAGGCGGCTTGTCGCGTCGGATGTGAAAGCCCGGGGCTTAACTCCGGGTCTGCATTCGATACGGGCAGGC TAGAGTGTGGTAGGGGAGATCGGAATTCCTGGTGTAGCGGTGAAATGCGCAGATATCAGGAGGAACACCGGTGGCGAAGGCGGAT CTCTGGGCCATTACTGACGCTGAGGAGCGAAAGCGTGGGGAGCGAACAGGATTAGATACCCTGGTAGTCCACGCCGTAAACGTTG GGAACTAGGTGTGGGTCACATTCCACGTGGTCCGCGCCGCAGCTAACGCATTAAGTTCCCCGCCTGGGGAGTACGGCCGCAAGGC TAAAACTCAAAGGAATTGACGGGGGCCCGCACAAGCAGCGGAGCATGTGGCTTAATTCGACGCAACGCGAAGAACCTTACCAAGG CTTGACATATACCGGAAACGTGCAGAGATGTACGCCCCCTTGTGGTCGGTATACAGGTGGTGCATGGTTGTCGTCAGCTCGTGTC GTGAGATGTTGGGTTAAGTCCCGCAACGAGCGCAACCCTCGTTCTGTGTTGCCAGCGGGTTATGCCGGGGACTCACAGGAGACTG CCGGGGTCAACTCGGAGGAAGGTGGGGACGACGTCAAATCATCATGCCCCTTATGTCTTGGGCTGCACACGTGCTACAATGGCCG GTACAATGAGCTGCGATACCGCGAGGTGGAGCGAATCTCAAAAAGCCGGTCTCAGTTCGGATTGGGGTCTGCAACTCGACCCCAT GAAGTCGGAGTTGCTAGTAATCGCAGATCAGCAGTGCTGCGGTGAATACGTTCCCGGGCCTTGTACACACCGCCCGTCACGTCAC GAAAGTCGGTAACACCCGAAGCCGGTGGCCTAACCCGTAAGGGACG |
| Strain Morphology Photos | |
| Morphological Description | Mycelia branch;luxuriant;filaments;vacuoles;old filaments into bundles;spore filaments fine;spore chain long;straight or curved spore pile near bare;four sides less;milky white;bean juice yellow on th |